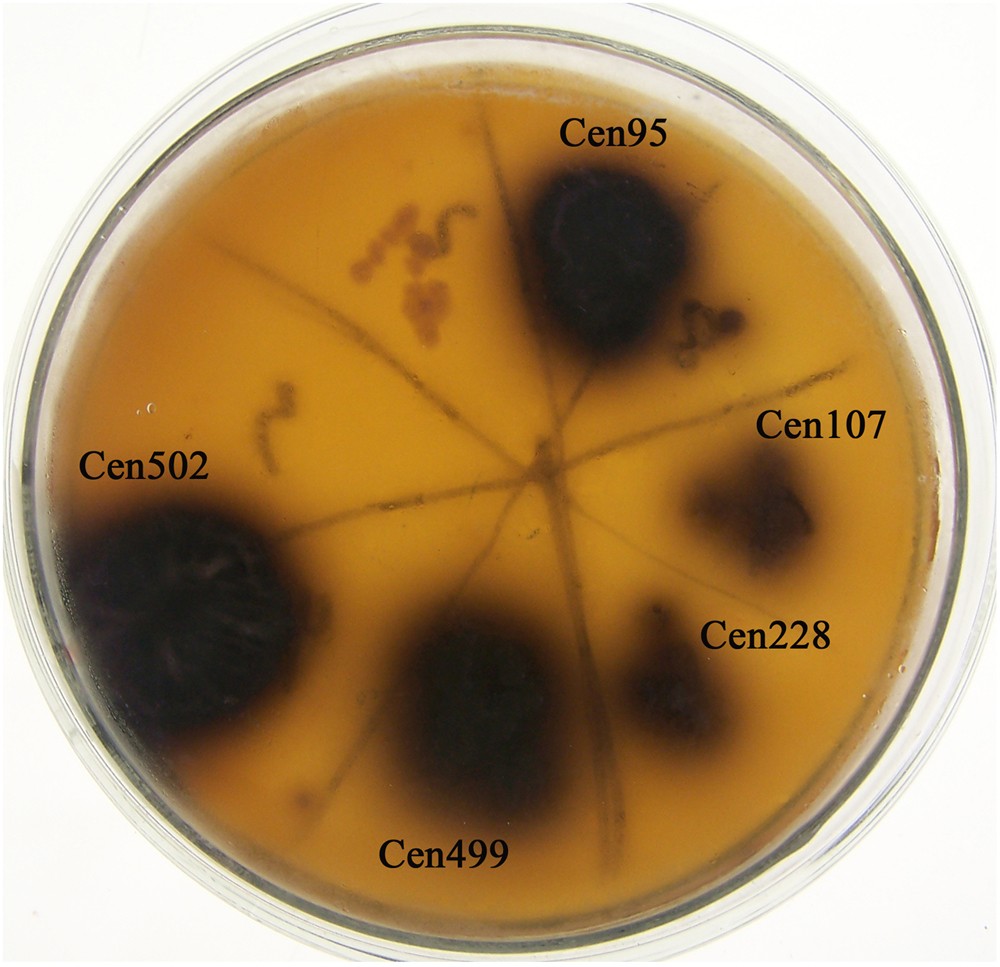
Figure 1

Figure 1
Screening of β-glucosidase activity in the metagenomic library on screening plates. Five clones expressing relatively strong β-glucosidase activity were obtained: Cen95, Cen107, Cen228, Cen499, and Cen502. Arrows indicate clone names. Clone Cen502 displayed the strongest activity and was selected for further research.